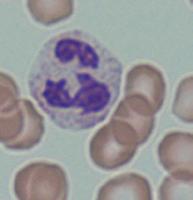

FISIOPATOLOGIA Bases da Medicina Clínica
Coordenação:
Anabela Mota Pinto I Ricardo Leão
Nuno Neuparth I Pedro Carreiro Martins
Roberto Roncon de Albuquerque I Adelino Leite Moreira



Coordenação:
Anabela Mota Pinto I Ricardo Leão
Nuno Neuparth I Pedro Carreiro Martins
Roberto Roncon de Albuquerque I Adelino Leite Moreira


Coordenação
AnAbelA MotA-Pinto
RicARdo leão
nuno neuPARth
PedRo cARReiRo-MARtins
Adelino leite-MoReiRA
RobeRto Roncon de AlbuqueRque

Lidel – Edições Técnicas, Lda.
www.lidel.pt
abreviaturas e acrónimos
1 Contributo da fisiopatologia na estruturação do raciocínio clínico 3
Roberto Roncon de Albuquerque, Adelino Leite-Moreira, Ricardo Leão, Anabela Mota-Pinto, Pedro Carreiro-Martins, Nuno Neuparth
2 Mapas conceptuais na aprendizagem da fisiopatologia 9
Nuno Neuparth, António Rendas, Roberto Roncon de Albuquerque, Pedro Carreiro-Martins, Patrícia Rosado-Pinto, Marta Fonseca
3 Considerações acerca do ensino e da aprendizagem da fisiopatologia: desde as origens até ao século xxi
António Rendas, Nuno Neuparth, Pedro Carreiro-Martins, Adelino Leite-Moreira, Roberto Roncon de Albuquerque, Ricardo Leão, Anabela Mota-Pinto
Rui Gradiz, Pedro Póvoa, Anabela Mota-Pinto 5 Radiação
Margarida Gonçalo, Ricardo Vieira
8.1 Alterações da motilidade digestiva e métodos de avaliação funcional
Inês Canha, Luís Abreu Novais
8.2 Doença do refluxo gastroesofágico
Madalena von Hafe, Pedro Pimentel Nunes
8.3 Síndrome de
Rui Gradiz
8.4 Doença ulcerosa
8.5
Jéssica de Lima Chaves, Pedro Pimentel Nunes
Mário Jorge Silva
Ana Bela Sarmento Ribeiro, Carla Barros Lima, Joana Azevedo, José Cortez
10.1 Aterosclerose e doença cardíaca isquémica 130
Pedro Gonçalves-Teixeira, Pedro de Araújo Gonçalves, Lino Gonçalves, Adelino Leite-Moreira
10.2 Doença cardíaca valvular 140
Pedro Gonçalves-Teixeira, Francisco Sampaio, Adelino Leite-Moreira
10.3 Insuficiência cardíaca 154
Pedro Gonçalves-Teixeira, Francisco Vasques-Nóvoa, João Pedro Ferreira, Ricardo Fontes-Carvalho, Adelino Leite-Moreira
10.4 Doenças do pericárdio 170
Pedro Gonçalves-Teixeira, Ricardo Ladeiras-Lopes, Adelino Leite-Moreira
10.5 Distúrbios do ritmo cardíaco 178
Pedro Gonçalves-Teixeira, Sílvia Marta Oliveira, Adelino Leite-Moreira
10.6 Doença vascular 191
Pedro Gonçalves-Teixeira, Marina Dias-Neto, Mário Santos, Adelino Leite-Moreira
10.7 Choque 199
Pedro Gonçalves-Teixeira, Roberto Roncon de Albuquerque, Manuel de Sousa Almeida, Adelino Leite-Moreira
10.8 Miocardiopatias 206
Pedro Gonçalves-Teixeira, Hélder Dores, Adelino Leite-Moreira
10.9 Cardiopatias congénitas 211
Joana de Oliveira Miranda, Pedro Gonçalves-Teixeira, Adelino Leite-Moreira
Ana Todo Bom, Pedro Carreiro-Martins, Roberto Roncon de Albuquerque, Nuno Neuparth, André Leite Moreira, André Lourenço, Alysson Carvalho, Miguel Ramalho Gonçalves, Carlos Robalo Cordeiro, Francisco Santos Dias, Beatriz Alves
12.1 Alterações das funções glomerular e tubular
Luís Mendonça
12.2 Alterações do equilíbrio hidroeletrolítico e ácido-base
Carla Santos-Araújo
12.3 Lesão renal aguda
Miguel Bigotte Vieira, Aníbal Ferreira
12.4 Doença renal crónica
Rui Alves, Luís Rodrigues
Lèlita Santos, Carmen Brás Silva, João Sérgio Neves, Marta Borges Canha
14.2
14.3
14.4
Luís Miguel Cardoso
João Sérgio Neves
Luís Miguel Cardoso, Carolina Moreno
Carolina Moreno
14.5 Fisiopatologia da glândula
14.6
14.7
14.8
Marta Borges Canha
João Sérgio Neves, Marta Borges Canha
Marta Borges Canha, João Sérgio Neves
Catarina Limbert
Carlos Rabaça, Carlos Martins da Silva, Francisco Cruz, Tiago Rodrigues, Alberto Costa Silva, Duarte Vieira e Brito, Ricardo Leão
Joaquim Alves da Silva, Marcelo Mendonça, Gonçalo Cotovio, Francisca Sá, André Caetano, Ana Barbosa Fernandes, Albino Jorge Oliveira-Maia, Miguel Viana-Baptista
Ana Bento da Silva, Maria Helena Lourenço, Sandra Falcão, Jaime da Cunha Branco
Rita Pinto Proença, Ana Filipa Moleiro, Margarida Ribeiro, Rodrigo Vilares Morgado, Amândio Rocha Sousa
Margarida Gonçalo, Joana Calvão da Silva, Sara Todo-Bom Costa, Frederico Regateiro
André Leite Moreira, André Lourenço, Anabela Mota-Pinto
Marta Pimenta, André Leite Moreira, André Lourenço, Nuno Matias Pereira, Anabela Mota-Pinto
Susana Sousa
Anabela Mota-Pinto, Sofia do Vale Pereira, Paulo Castro Chaves, Amália Botelho
Joana Apolónio, João Lobo, Mónica Teotónio Fernandes, Tito Teles Jesus, Joana Paredes, Ricardo Leão
Adelino Leite-Moreira
Professor Catedrático e Diretor do Departamento de Cirurgia e Fisiologia da Faculdade de Medicina da Universidade do Porto; Diretor do Serviço de Cirurgia Cardiotorácica do Hospital de São João da Unidade Local de Saúde de São João, EPE; Coordenador de Cirurgia Cardíaca nos Hospitais CUF Porto e CUF Coimbra; Coordenador da Linha Temática Cardiovascular do RISE-Health.
Anabela Mota-Pinto
Professora Catedrática de Fisiopatologia na Faculdade de Medicina da Universidade de Coimbra; Diretora do Instituto de Patologia Geral da Faculdade de Medicina da Universidade de Coimbra; Investigadora do Instituto de Investigação Clínica e Biomédica de Coimbra; Coordenadora do Grupo Biomarkers & Inflammation da Linha do Ambiente no Centro de Investigação em Meio Ambiente, Genética e Oncobiologia.
nuno neuparth
Professor Catedrático de Fisiopatologia na NOVA Medical School - Faculdade de Ciências Médicas da Universidade NOVA de Lisboa; Assistente Hospitalar de Imunoalergologia na Unidade Local de Saúde de São José, EPE; Membro Integrado do Comprehensive Health Research Centre.
Pedro Carreiro-Martins
Professor Associado com Agregação na NOVA Medical School – Faculdade de Ciências Médicas da Universidade NOVA de Lisboa; Assistente Hospitalar Graduado de Imunoalergologia na Unidade Local de Saúde de São José, EPE; Investigador no Comprehensive Health Research Centre.
Ricardo Leão
Professor Auxiliar de Fisiopatologia na Faculdade de Medicina da Universidade de Coimbra; Panel Member of the Testicular Cancer Guidelines – European Association of Urology; ESMO-EURACAN Committee for Testicular Cancer Clinical Practice.
Roberto Roncon de Albuquerque
Professor Associado Convidado do Departamento de Cirurgia e Fisiologia da Faculdade de Medicina da Universidade do Porto; Especialista em Medicina Interna e Medicina Intensiva na Unidade Local de Saúde de São João, EPE.
Fisiopatologia – bases da medicina clínica
Alberto Costa silva
Assistente Convidado na Faculdade de Medicina da Universidade do Porto; Interno de Urologia na Unidade Local de Saúde de São João, EPE.
Albino Jorge Oliveira-Maia
Professor Auxiliar Convidado na NOVA Medical School – Faculdade de Ciências Médicas da Universidade NOVA de Lisboa; Diretor da Unidade e Laboratório de Neuropsiquiatria da Fundação Champalimaud.
Alysson Carvalho
Professor no Instituto de Biofísica Carlos Chagas Filho da Universidade Federal do Rio de Janeiro; Médico Radiologista; Pesquisador no Instituto D'Or de Pesquisa e Ensino; Investigador na Unidade de Investigação e Desenvolvimento Cardiovascular do Research and Development Center.
Amália Botelho
Professora Auxiliar Aposentada na NOVA Medical School – Faculdade de Ciências Médicas da Universidade NOVA de Lisboa (NMS|FCM-UNL); Regente da Unidade Curricular do Doente Idoso na NMS|FCM-UNL entre 2014 e 2020.
Amândio Rocha sousa
Professor Catedrático na Faculdade de Medicina da Universidade do Porto; Diretor do Serviço de Oftalmologia da Unidade Local de Saúde de São João, EPE.
Ana Barbosa Fernandes
Professora Auxiliar Convidada na NOVA Medical School – Faculdade de Ciências Médicas da Universidade NOVA de Lisboa; Investigadora na Fundação Champalimaud.
Ana Bela sarmento Ribeiro
Professora Catedrática na Faculdade de Medicina da Universidade de Coimbra; Consultora e Assistente Hospitalar Graduada de Hematologia Clínica na Unidade Local de Saúde de Coimbra, EPE; Diretora das Clínicas Universitárias de Hematologia e Oncologia da Faculdade de Medicina da Universidade de Coimbra.
Ana Bento da silva
Estudante de Doutoramento no Departamento de Reumatologia do Leiden University Medical Center, Leiden, Países Baixos.
Ana Filipa Moleiro
Assistente Convidada na Faculdade de Medicina da Universidade do Porto; Assistente Hospitalar de Oftalmologia na Unidade Local de Saúde de São João, EPE.
Ana Todo Bom
Professora Catedrática e Regente da Unidade Curricular de Alergologia da Faculdade de Medicina da Universidade de Coimbra; Assistente Hospitalar Graduada Sénior e Diretora do Serviço de Imunoalergologia da Unidade Local de Saúde de Coimbra, EPE.
André Caetano
Professor Auxiliar Convidado na NOVA Medical School – Faculdade de Ciências Médicas da Universidade NOVA de Lisboa; Assistente Hospitalar de Neurologia no Hospital de Egas Moniz da Unidade Local de Saúde Lisboa Ocidental, EPE.
André Leite Moreira
Professor Auxiliar na Faculdade de Medicina da Universidade do Porto; Assistente Hospitalar de Anestesiologia na Unidade Local de Saúde de São João, EPE.
André Lourenço
Professor Associado na Faculdade de Medicina da Universidade do Porto; Assistente Hospitalar Graduado de Anestesiologia na Unidade Local de Saúde de São João, EPE.
Aníbal Ferreira
Professor Associado Convidado na NOVA Medical School – Faculdade de Ciências Médicas da Universidade NOVA de Lisboa; Assistente Hospitalar Graduado Sénior de Nefrologia no Hospital de Curry Cabral da Unidade Local de Saúde de São José, EPE.
António Bugalho
Professor Auxiliar Convidado na NOVA Medical School – Faculdade de Ciências Médicas da Universidade NOVA de Lisboa; Médico Pneumologista no Hospital CUF Tejo; Investigador no Comprehensive Health Research Centre.
António Rendas
Professor Emérito na NOVA Medical School – Faculdade de Ciências Médicas da Universidade NOVA de Lisboa.
Beatriz Alves
Assistente Convidada na Faculdade de Medicina da Universidade do Porto; Interna de Formação Geral na Unidade Local de Saúde da Cova da Beira, EPE.
Carla Barros Lima
Médica Especialista em Hematologia Clínica na Medicentro – Clínica de Especialidades, Mindelo, Cabo Verde.
Carla santos-Araújo
Professora Auxiliar Convidada na Faculdade de Medicina da Universidade do Porto; Diretora do Departamento de Nefrologia e Centros Internacionais de Excelência – Diaverum/M42.
Carlos Martins da silva
Professor Catedrático Convidado na Faculdade de Medicina da Universidade do Porto; Assistente Hospitalar Graduado Sénior de Urologia na Unidade Local de Saúde de São João, EPE.
Carlos Rabaça
Professor na Faculdade de Medicina da Universidade de Coimbra; Assistente Hospitalar Graduado Sénior de Urologia e Diretor do Serviço de Urologia do Instituto Português de Oncologia de Coimbra Francisco Gentil, EPE.
Fisiopatologia – bases da medicina clínica
Carlos Robalo Cordeiro
Diretor da Faculdade de Medicina da Universidade de Coimbra; Diretor do Serviço de Pneumologia da Unidade Local de Saúde de Coimbra, EPE.
Carmen Brás silva
Professora Auxiliar na Faculdade de Medicina da Universidade do Porto; Diretora do Mestrado em Nutrição Clínica da Faculdade de Ciências da Nutrição e Alimentação da Universidade do Porto.
Carolina Moreno
Professora Auxiliar Convidada na Faculdade de Medicina da Universidade de Coimbra; Assistente Hospitalar Graduada de Endocrinologia nos Hospitais da Universidade de Coimbra da Unidade Local de Saúde de Coimbra, EPE.
Catarina Limbert
Professora Catedrática na NOVA Medical School – Faculdade de Ciências Médicas da Universidade NOVA de Lisboa; Assistente Hospitalar Graduada de Pediatria na Unidade de Endocrinologia Pediátrica do Hospital de Dona Estefânia da Unidade Local de Saúde de São José, EPE.
daniel Moreira-Gonçalves
Professor Auxiliar na Faculdade de Desporto da Universidade do Porto (FADEUP); Membro do Centro de Investigação em Atividade Física, Saúde e Lazer da FADEUP; Coordenador do Laboratório de Fisiologia do Desporto da FADEUP.
duarte Vieira e Brito
Professor Convidado na Escola de Medicina da Universidade do Minho.
Francisca sá
Assistente Convidada na NOVA Medical School – Faculdade de Ciências Médicas da Universidade NOVA de Lisboa; Assistente Hospitalar Graduada de Neurologia e Neurofisiologista no Hospital de Egas Moniz da Unidade Local de Saúde Lisboa Ocidental, EPE.
Francisco Cruz
Professor Catedrático na Faculdade de Medicina da Universidade do Porto; Assistente Hospitalar Sénior de Urologia na Unidade Local de Saúde de São João, EPE.
Francisco sampaio
Professor Auxiliar Convidado na Faculdade de Medicina da Universidade do Porto; Cardiologista na Unidade Local de Saúde de Gaia/Espinho, EPE.
Francisco santos dias
Assistente Convidado na Faculdade de Medicina da Universidade do Porto; Interno de Medicina Intensiva na Unidade Local de Saúde de São João, EPE.
Francisco Vasques-nóvoa
Assistente Convidado na Faculdade de Medicina da Universidade do Porto; Assistente Hospitalar na Unidade Local de Saúde de São João, EPE.
Frederico Regateiro
Professor Auxiliar Convidado na Faculdade de Medicina da Universidade de Coimbra; Assistente Hospitalar de Imunoalergologia na Unidade Local de Saúde de Coimbra, EPE; Investigador Integrado no Centro de Inovação em Biomedicina e Biotecnologia da Universidade de Coimbra; Investigador Colaborador no Centro de Investigação em Ciências da Saúde da Universidade da Beira Interior e no RISE-Health.
Gonçalo Cotovio
Professor Auxiliar Convidado na NOVA Medical School – Faculdade de Ciências Médicas da Universidade NOVA de Lisboa; Psiquiatra e Investigador da Unidade de Neuropsiquiatria na Fundação Champalimaud.
Hélder dores
Professor Auxiliar e Regente da Unidade Curricular de Fisiopatologia 2 na NOVA Medical School –Faculdade de Ciências Médicas da Universidade NOVA de Lisboa; Assistente Hospitalar Graduado de Cardiologia; Coordenador da Cardiologia Clínica do Hospital da Luz Lisboa; Investigador do Comprehensive Health Research Centre.
Inês Canha
Assistente Convidada na NOVA Medical School – Faculdade de Ciências Médicas da Universidade NOVA de Lisboa; Assistente Hospitalar de Gastrenterologia na Unidade Local de Saúde de São José, EPE.
Jaime da Cunha Branco
Professor Catedrático na NOVA Medical School – Faculdade de Ciências Médicas da Universidade NOVA de Lisboa; Diretor do Serviço de Reumatologia do Hospital de Egas Moniz da Unidade Local de Saúde de Lisboa Ocidental, EPE.
Jéssica de Lima Chaves
Assistente Hospitalar de Gastrenterologia na Unidade Local de Saúde de Trás-os-Montes e Alto Douro, EPE.
Joana Apolónio
Professora Auxiliar Convidada na Faculdade de Medicina e Ciências Biomédicas da Universidade do Algarve; Investigadora no Grupo Epigenetics in Human Disease, do Algarve Biomedical Center Research Institute da Universidade do Algarve.
Joana Azevedo
Assistente Convidada na Faculdade de Medicina da Universidade de Coimbra; Assistente Hospitalar Graduada de Hematologia Clínica na Unidade Local de Saúde de Coimbra, EPE.
Joana Calvão da silva
Médica Dermatologista de Dermatovenereologia na Unidade Local de Saúde de Coimbra, EPE.
Joana de Oliveira Miranda
Professora Auxiliar Convidada na Faculdade de Medicina da Universidade do Porto; Diretora do Serviço de Cardiologia Pediátrica no Centro Materno-Infantil do Norte Albino Aroso da Unidade Local de Saúde de Santo António, EPE.
Fisiopatologia – bases da medicina clínica
Joana Paredes
Professora Afiliada na Faculdade de Medicina da Universidade do Porto; Líder do Grupo Cancer Metastasis do i3S – Instituto de Investigação e Inovação em Saúde da Universidade do Porto.
João Lobo
Professor Auxiliar Convidado no Instituto de Ciências Biomédicas Abel Salazar da Universidade do Porto; Assistente Hospitalar de Anatomia Patológica no Instituto Português de Oncologia (IPO) do Porto; Investigador Júnior do Grupo de Epigenética e Biologia do Cancro do Centro de Investigação do IPO do Porto.
João Pedro Ferreira
Professor Agregado na Faculdade de Medicina da Universidade do Porto.
João sérgio neves
Professor Auxiliar Convidado na Faculdade de Medicina da Universidade do Porto; Assistente Hospitalar de Endocrinologia na Unidade Local de Saúde de São João, EPE.
Joaquim Alves da silva
Professor Auxiliar Convidado na NOVA Medical School – Faculdade de Ciências Médicas da Universidade NOVA de Lisboa; Investigador Principal do Grupo de Disfunção de Circuitos Neuronais da Fundação Champalimaud.
José Cortez ✝
Professor Convidado na NOVA Medical School – Faculdade de Ciências Médicas da Universidade NOVA de Lisboa.
Lèlita santos
Professora Associada com Agregação na Faculdade de Medicina da Universidade de Coimbra; Assistente Hospitalar Graduada Sénior de Medicina Interna na Unidade Local de Saúde de Coimbra, EPE.
Lino Gonçalves
Professor Catedrático na Faculdade de Medicina da Universidade de Coimbra; Diretor do Serviço de Cardiologia da Unidade Local de Saúde de Coimbra, EPE.
Luís Abreu novais
Docente Afiliado na NOVA Medical School – Faculdade de Ciências Médicas da Universidade NOVA de Lisboa (NMS|FCM-UNL); Diretor do Laboratório de Neurogastrenterologia e Motilidade Digestiva na NMS|FCM-UNL.
Luís Mendonça
Assistente Convidado na Faculdade de Medicina da Universidade do Porto; Assistente Hospitalar de Nefrologia na Unidade Local de Saúde de São João, EPE.
Luís Miguel Cardoso
Assistente Hospitalar de Endocrinologia na Unidade Local de Saúde de Coimbra, EPE; Investigador no i3S – Instituto de Investigação e Inovação em Saúde da Universidade do Porto.
Luís Rodrigues
Assistente Convidado na Faculdade de Medicina da Universidade de Coimbra; Assistente Hospitalar de Nefrologia na Unidade Local de Saúde de Coimbra, EPE.
Madalena von Hafe
Assistente Convidada na Faculdade de Medicina da Universidade do Porto; Médica Pediatra na Unidade Local de Saúde de São João, EPE.
Manuel de sousa Almeida
Professor Auxiliar Convidado na NOVA Medical School – Faculdade de Ciências Médicas da Universidade NOVA de Lisboa; Assistente Hospitalar Graduado Sénior de Cardiologia na Unidade Local de Saúde de Lisboa Ocidental, EPE.
Marcelo Mendonça
Professor Auxiliar Convidado na NOVA Medical School – Faculdade de Ciências Médicas da Universidade NOVA de Lisboa; Médico Neurologista e Investigador Pós-Doutoral na Fundação Champalimaud.
Margarida Gonçalo
Professora Auxiliar na Faculdade de Medicina da Universidade de Coimbra; Diretora do Serviço de Dermatologia do Hospital da Universidade de Coimbra da Unidade Local de Saúde de Coimbra, EPE; Secretária-geral da European Academy of Dermatology and Venereology.
Margarida Ribeiro
Assistente Convidada na Faculdade de Medicina da Universidade do Porto; Assistente Hospitalar de Oftalmologia na Unidade Local de Saúde do Alto Ave, EPE.
Maria Helena Lourenço
Assistente Hospitalar de Reumatologia na Unidade Local de Saúde de Entre Douro e Vouga, EPE.
Marina dias-neto
Professora Auxiliar Convidada na Faculdade de Medicina da Universidade do Porto; Assistente Hospitalar de Angiologia e Cirurgia Vascular na Unidade Local de Saúde de São João, EPE.
Mário Jorge silva
Assistente Convidado na NOVA Medical School – Faculdade de Ciências Médicas da Universidade NOVA de Lisboa; Médico Especialista em Gastrenterologia e Subespecialista em Hepatologia na Unidade Local de Saúde de São José, EPE.
Mário santos
Professor Associado Convidado no Instituto de Ciências Biomédicas Abel Salazar da Universidade do Porto; Assistente Hospitalar Graduado na Unidade de Doença Vascular Pulmonar da Unidade Local de Saúde de Santo António, EPE.
Marta Borges Canha
Assistente Convidada na Faculdade de Medicina da Universidade do Porto; Médica Especialista em Endocrinologia e Nutrição na Unidade Local de Saúde de São João, EPE.
Fisiopatologia – bases da medicina clínica
Marta Fonseca
Professora Auxiliar Convidada na NOVA Medical School - Faculdade de Ciências Médicas da Universidade NOVA de Lisboa; Especialista em Medicina Geral e Familiar no Hospital CUF Tejo.
Marta Pimenta
Assistente Hospitalar de Anestesiologia na Unidade Local de Saúde de São José, EPE.
Miguel Bigotte Vieira
Assistente Convidado na NOVA Medical School – Faculdade de Ciências Médicas da Universidade NOVA de Lisboa; Médico Nefrologista no Hospital de Curry Cabral na Unidade Local de Saúde de São José, EPE.
Miguel Ramalho Gonçalves
Professor Associado na Faculdade de Medicina da Universidade do Porto; Médico Fisioterapeuta na Unidade Local de Saúde de São João, EPE; Investigador na Unidade de Investigação e Desenvolvimento Cardiovascular no Research and Development Center da Faculdade de Medicina da Universidade do Porto.
Miguel Viana-Baptista
Professor Auxiliar Convidado e Regente da Unidade Curricular de Neurologia na NOVA Medical School – Faculdade de Ciências Médicas da Universidade NOVA de Lisboa; Diretor do Serviço de Neurologia do Hospital de Egas Moniz da Unidade Local de Saúde de Lisboa Ocidental, EPE.
Mónica Teotónio Fernandes
Professora Adjunta Convidada na Escola Superior de Saúde da Universidade do Algarve; Investigadora Principal no Algarve Biomedical Center Research Institute da Universidade do Algarve.
nuno Matias Pereira
Diretor do Serviço de Anestesiologia da Unidade Local de Saúde do Litoral Alentejano, EPE.
Patrícia Rosado-Pinto
Professora Auxiliar Convidada Aposentada na NOVA Medical School - Faculdade de Ciências Médicas da Universidade NOVA de Lisboa.
Paulo Castro Chaves
Professor Associado Convidado na Faculdade de Medicina da Universidade do Porto; Assistente Hospitalar Graduado de Medicina Interna na Unidade Local de Saúde de São João, EPE.
Pedro de Araújo Gonçalves
Professor Associado com Agregação e Regente da Unidade Curricular do Coração e Pulmão na NOVA Medical School – Faculdade de Ciências Médicas da Universidade NOVA de Lisboa; Coordenador do Centro de Cardiologia de Intervenção no Hospital da Luz Lisboa.
Pedro Gonçalves-Teixeira
Assistente Convidado na Faculdade de Medicina da Universidade do Porto; Coordenador do Hospital de Dia de Cardiologia, da Consulta de Insuficiência Cardíaca Avançada e da Consulta de Cardio-Oncologia, e Médico na Unidade de Cuidados Intensivos Coronários da Unidade Local de Saúde de Gaia/Espinho, EPE.
Pedro Pimentel nunes
Professor Catedrático Convidado na Faculdade de Medicina da Universidade do Porto; Diretor e Médico Gastrenterologista da Unilabs Portugal.
Pedro Póvoa
Professor Catedrático na NOVA Medical School – Faculdade de Ciências Médicas da Universidade NOVA de Lisboa; Professor Adjunto na Research Unit of Clinical Epidemiology, Department of Clinical Research do Odense University Hospital, Dinamarca; Assistente Graduado Sénior de Medicina Intensiva no Hospital de São Francisco Xavier da Unidade Local de Saúde de Lisboa Ocidental, EPE; Investigador no Comprehensive Health Research Centre, Lisboa; Pesquisador no D’Or Institute for Research and Education (IDOR), Rio de Janeiro, Brasil.
Ricardo Castro Ferreira
Professor Auxiliar na Faculdade de Medicina da Universidade do Porto; Cirurgião Vascular no Hospital Lusíadas Porto.
Ricardo Fontes-Carvalho
Professor Catedrático Convidado na Faculdade de Medicina da Universidade do Porto; Diretor do Serviço de Cardiologia da Unidade Local de Saúde de Gaia/Espinho, EPE.
Ricardo Ladeiras-Lopes
Professor Auxiliar Convidado na Faculdade de Medicina da Universidade do Porto; Médico Cardiologista no Hospital da Luz.
Ricardo Vieira
Professor Associado com Agregação de Dermatologia na Faculdade de Medicina da Universidade de Coimbra.
Rita Pinto Proença
Assistente Hospitalar de Oftalmologia na Unidade Local de Saúde de São José, EPE; Doutoranda na Faculdade de Medicina da Universidade de Lisboa.
Rodrigo Vilares Morgado
Assistente Convidado na Faculdade de Medicina da Universidade do Porto; Assistente Hospitalar de Oftalmologia na Unidade Local de Saúde de São João, EPE.
Rui Alves
Professor Associado com Agregação na Faculdade de Medicina da Universidade de Coimbra; Assistente Hospitalar Graduado Sénior de Nefrologia na Unidade Local de Saúde de Coimbra, EPE.
Rui Gradiz
Professor Auxiliar Convidado na Faculdade de Medicina da Universidade de Coimbra.
sandra Falcão
Professora Auxiliar Convidada na NOVA Medical School – Faculdade de Ciências Médicas da Universidade NOVA de Lisboa; Diretora do Serviço de Reumatologia do Hospital Beatriz Ângelo da Unidade Local de Saúde de Loures/Odivelas, EPE.
Fisiopatologia – bases da medicina clínica
sara Todo-Bom Costa
Assistente Hospitalar de Pediatria na Unidade Local de Saúde de Santa Maria, EPE; Doutoranda na Faculdade de Medicina da Universidade de Lisboa.
sílvia Marta Oliveira
Assistente Convidada na Faculdade de Medicina da Universidade do Porto; Assistente Hospitalar Graduada de Cardiologia na Unidade Local de Saúde de Matosinhos, EPE.
sofia do Vale Pereira
Assistente Convidada na Faculdade de Medicina da Universidade de Coimbra; Especialista em Medicina Geral e Familiar; Mestre em Medicina pela Faculdade de Medicina da Universidade de Coimbra.
susana sousa
Assistente Convidada na NOVA Medical School – Faculdade de Ciências Médicas da Universidade NOVA de Lisboa; Médica Pneumologista no Hospital CUF Tejo e Hospital CUF Descobertas; Investigadora no Comprehensive Health Research Centre.
Tiago Rodrigues
Coordenador Clínico de Urologia do Hospital Cruz Vermelha; Fundador GUPURO.
Tito Teles Jesus
Investigador no i3S – Instituto de Investigação e Inovação em Saúde da Universidade do Porto.
O livro Fisiopatologia – Bases da medicina clínica nasceu da colaboração entre as Faculdades de Medicina da Universidade de Coimbra, da Universidade NOVA de Lisboa e da Universidade do Porto, instituições que compartilham um compromisso unificado com a excelência académica e a formação de profissionais de saúde.
É, assim, o resultado do esforço conjunto de médicos dedicados ao ensino e à compreensão das bases da fisiopatologia.
Foi elaborado para proporcionar aos alunos de medicina uma abordagem clara e abrangente da fisiopatologia. Os capítulos foram estruturados de forma lógica e sequencial, permitindo uma progressão gradual desde os conceitos fundamentais até aos de maior complexidade. Procurou-se também que cada capítulo fosse, sempre que possível, enriquecido com ilustrações claras, exemplos clínicos relevantes e estudos de caso que auxiliem na aplicação prática do conhecimento.
Os autores são especialistas de renome nas respetivas áreas, aliando o conhecimento clínico ao comprometimento com o ensino de qualidade. A fisiopatologia é o alicerce sobre o qual a medicina se constrói. É o estudo das alterações funcionais que ocorrem nos sistemas do organismo humano, quando confrontado com patologias e disfunções, incluindo também a sistematização das causas das doenças. Compreender os processos subjacentes às manifestações clínicas é essencial para o diagnóstico preciso, para o desenvolvimento de um plano de tratamento e para a investigação que está na base dos progressos médicos.
Foi nosso objetivo que esta obra não se limitasse a um livro de recolha de informação, mas que promovesse também uma compreensão profunda dos mecanismos subjacentes das doenças, estimulando o pensamento crítico e facilitando a consolidação do conhecimento. Esta é uma disciplina de “ponte” entre as ciências básicas e as clínicas que é essencial para estruturar o raciocínio clínico. Esperamos que este livro seja uma ferramenta valiosa na formação de uma nova geração de profissionais de saúde, comprometidos com a excelência clínica e científica; e que neles inspire uma paixão duradoura pelo entendimento das complexidades do corpo humano em estados de saúde e de doença.
Adelino Leite-Moreira
Anabela Mota-Pinto
Nuno Neuparth
Pedro Carreiro-Martins
Ricardo Leão
Roberto Roncon de Albuquerque (Coordenadores)
Médica
Roberto Roncon de Albuquerque, Adelino Leite-Moreira, Ricardo Leão, Anabela Mota-Pinto, Pedro Carreiro-Martins, Nuno Neuparth
Fisiopatologia – bases da medicina clínica
O raciocínio clínico é um processo cognitivo complexo subjacente à realização da atividade médica. Requer uma correta compreensão dos mecanismos de doença em termos de processos, químicos, biológicos e patológicos, de forma a identificar os sinais e sintomas-chave que permitam uma hierarquização de hipóteses explicativas e a tomada de decisões clínicas. O raciocínio clínico é um elemento central das competências médicas.
Neste capítulo, será descrito o papel da fisiopatologia nos vários passos do raciocínio clínico e a importância da integração dos princípios da fisiopatologia na prática clínica diária.
R
o
o CLÍNICo, guidelines E F I s I o PATo Log IA
A prática clínica em medicina exige o desenvolvimento de competências teóricas e práticas que permitem o contacto com o doente, a realização da anamnese, a realização do exame físico, o estabelecimento de um diagnóstico provisório, a escolha dos métodos complementares de diagnóstico e a sua interpretação, bem como a definição de um plano terapêutico e plano de seguimento. Em todos estes passos, a compreensão dos mecanismos subjacentes às doenças e a forma como estes interagem com a normal fisiologia humana é essencial. A fisiopatologia, como área do saber que descreve o impacto do estado de doença na normal fisiologia humana, tem um papel basilar na estruturação do raciocínio clínico. Ao integrar conhecimentos da fisiologia, da anatomia, da bioquímica, da biopatologia e das várias áreas médicas (neurologia, cardiologia, endocrinologia, nefrologia, etc.), a fisiopatologia estabelece-se como um elemento basilar do raciocínio clínico.
Com o desenvolvimento das metodologias de investigação, da estatística e da epidemiologia, a prática de “medicina baseada na evidência” tornou-se o padrão da atividade clínica na maior parte das áreas médicas. As guidelines, ou orientações clínicas, como elementos-chave da medicina baseada na evidência têm um papel central na prática da medicina
contemporânea. Em parte, devido ao crescimento em número e qualidade das orientações clínicas, os currículos médicos pré-graduados e pós-graduados foram, em muitos casos, adaptados para diminuírem a ênfase na fisiopatologia e aumentarem a ênfase no ensino das guidelines mais contemporâneas.
Apesar dos méritos da disseminação de guidelines na elevação do padrão de qualidade da prática clínica e na garantia de uma medicina segura e de excelência, o conhecimento das guidelines não substitui a necessidade de desenvolver competências fisiopatológicas. Em primeiro lugar, a fisiopatologia, ao privilegiar a compreensão e o raciocínio à simples memorização, permite melhorar a assimilação e memorização dos conhecimentos médicos; ou seja, mesmo a memorização e aplicação prática das melhores guidelines é melhorada pela compreensão da fisiopatologia das doenças sobre as quais estas se focam. Em segundo lugar, o ensino médico exclusivamente baseado em guidelines é limitado no tempo. De acordo com a melhor evidência disponível, as guidelines são continuamente revistas e atualizadas, fazendo com que informação atualmente válida possa ser incompleta ou mesmo incorreta a curto/médio prazo. Por outro lado, a compreensão da fisiopatologia permite ao clínico obter uma plasticidade e flexibilidade de conhecimento que lhe permite compreender de que forma os novos ensaios clínicos e estudos epidemiológicos se integram nos mecanismos de doença já previamente estabelecidos. Por fim, a medicina baseada em guidelines, quando praticada de forma “cega”, pode levar a que doentes com apresentações similares, mas com mecanismos fisiopatológicos subjacentes diferentes, sejam abordados da mesma forma com resultados clínicos díspares. Não raramente, manifestações de doenças similares necessitam de abordagens diferentes de acordo com os mecanismos fisiopatológicos subjacentes. O objetivo do desenvolvimento de guidelines deve ser recomendar a melhor prática de acordo com o contexto clínico específico do doente, e não substituir o raciocínio clínico.
A melhor prática médica exige a obtenção de competências de raciocínio clínico. Estas competências dependem em grande parte da
Fisiopatologia – bases da medicina clínica
a lterações da motilidade digestiva e métodos de avaliação F u N cio N al
inês canha, luís abreu Novais
A motilidade digestiva é assegurada por um conjunto de contrações musculares coordena das, cuja eficácia depende das células musculares lisas intestinais, das células intersticiais de Cajal (células especializadas que atuam como pacemaker das células musculares lisas) e do plexo nervoso mioentérico (PNM) ou de Auerbach. Este último compreende neurónios excitatórios que promovem a contração e ini bitórios que, via peptídeo intestinal vasoativo (VIP) e óxido nítrico (NO), são necessários para o relaxamento dos esfíncteres. A sua atividade é controlada pelo sistema nervoso simpático (SNS) e parassimpático (SNP) e por estímulos hormonais.
As perturbações da motilidade digestiva resul tam da inadequada contração das células musculares lisas ou de alterações do seu con trolo neuronal e hormonal.
1. Fisiopatologia da motilidade eso Fágica
O processo de deglutição inicia‑se por uma fase voluntária oral (propulsão do bolo ali mentar da boca para a orofaringe), seguindo ‑se duas fases involuntárias, a orofaríngea e a esofágica. A orofaringe e o terço superior do esófago, constituídos por músculo estriado, são controlados pela estimulação vagal cen tral, originada no núcleo ambíguo (tronco encefálico), enquanto os dois terços inferiores do esófago são constituídos por músculo liso disposto em fibras musculares circulares e
longitudinais e têm uma coordenação central pelo núcleo motor dorsal (nervo vago) e perifé rica através do PNM.
O corpo esofágico, o esfíncter esofágico supe rior (EES) e o esfíncter esofágico inferior (EEI) agem de forma coordenada para que se dê a deglutição. Quando esta se inicia, o EES relaxa, seguindo‑se o início dos movimentos peristálti cos do corpo esofágico. Aproximadamente 0,5 a 1,4 segundos após o pico de pressão hipofarín gea, o EEI relaxa. As ondas peristálticas esofági cas condicionam o movimento do bolo alimentar para o estômago, dando origem a uma onda de contração ao longo do esófago com cerca de 8 a 10 segundos (peristalse primária). Caso per sista o bolo alimentar no esófago, a distensão provocada pelo mesmo origina outro tipo de ondas (peristalse secundária).
A manometria esofágica é um método de ava liação da motilidade do esófago que consiste no posicionamento de um cateter intraluminal com sensores de pressão no seu interior, onde o EES e EEI surgem como zonas de alta pressão que relaxam com a deglutição e o corpo do esófago exibe contrações peristálticas. Com os avanços tecnológicos, a manometria esofágica de alta resolução (MEAR) (Figura 8.1.1A) tornou‑se o método gold standard no diagnóstico de dis túrbios da motilidade esofágica, definidos pela classificação de Chicago (última versão: 4.0).
A MEAR permite a avaliação do relaxamento do EEI através da pressão média integrada de relaxamento (IRP), da motilidade esofágica atra vés do integral de contração distal (DCI), que inclui a amplitude, duração e extensão da onda




Figura 8.1.1 – manometria esofágica de alta resolução. (a) traçado normal: o movimento de deglutição inicia uma contração peristáltica progressiva e o eei relaxa completamente a uma irp normal (≤15 mmHg); (B) acalásia tipo i: irp acima do limite superior do normal com 100% de falência de peristalse; (c) espasmo esofágico distal: ld inferior a 4,5 segundos com irp normal; (d) esófago hipercontrátil: dci superior a 8000 mmHg‑s‑cm com irp normal. (imagens gentilmente cedidas pelo laboratório de Neurogastrenterologia e motilidade digestiva – lNmd, Nova medical school – Fcm, universidade Nova de lisboa)
1.3.2 espasmo esofágico distal
O espasmo esofágico distal caracteriza‑se pela existência de contrações espásticas ou prema turas no esófago distal em ≥20% das degluti ções (com LD menor do que 4,5 segundos e DCI superior a 450 mmHg), com relaxamento normal do EEI (Figura 8.1.1C).
A sua etiopatogenia, embora pouco com preendida, resulta do predomínio das vias excitatórias colinérgicas em relação às vias inibitórias do NO, que atuam sobre o PNM. Em condições fisiológicas, os estímulos inibitórios
predominam na região distal do esófago, de forma a criar um maior período de latência que permita que a onda peristáltica progrida distal mente. Em situações patológicas, verifica‑se um predomínio da ação das vias excitatórias colinérgicas que provocam uma diminuição deste intervalo, com consequentes contrações prematuras espontâneas no esófago distal. Os doentes apresentam tipicamente disfagia episódica para alimentos sólidos e líquidos e dor torácica.
Tabela 9.1 – Componentes celulares do sangue, principais características e funções.

PLAQUETAS

ERITRÓCITOS
NEUTRÓFILO

LINFÓCITO

MONÓCITO

EOSINÓFILO

BASÓFILO
280 ± 130 x 109/L
♂ 5,0 ± 0,5 x 1012/L ou
♀ 4,3 ± 0,5 x 1012/L
2,0 – 7,0 x 109/L (40 – 80%)
1,5-3 μm
Fragmentos celulares citoplasmáticos, granulares
1,0 – 3,0 x 109/L (20 – 40%)
6-8 μm
Disco bicôncavo, halo central mais pálido, ausência de núcleo
Função na hemóstase; libertação de fatores envolvidos na cicatrização e reparação tecidular
Transporte de O2
0,2 – 1,0 x 109/L (2 – 10%)
12-14 μm
Citoplasma granular, núcleo com dois a cinco lóbulos
6 -9 μm
Células pequenas, citoplasma escasso
10–14 μm
Linfócitos ativados
<20 μm
Núcleo excêntrico reniforme, citoplasma abundante, finamente granular e vacuolado
Imunidade inata, inflamação, quimiotaxia, fagocitose, libertação de citocinas (resposta inflamatória e antimicrobiana), NET
• Linfócitos B: imunidade humoral, produção de Ac (plasmócitos)
• Linfócitos T: imunidade celular
• Linfócitos NK: células linfoides inatas
Imunidade inata; fagocitose, apresentação antigénica, produção de citocinas; migração para tecidos (macrófagos)
0,02 – 0,5 x 109/L (1 – 6%)
12-17 μm
Núcleo bilobado, grânulos citoplasmáticos eosinofílicos (alaranjados)
14-16 μm
0,02 – 0,1 x 109/L (<1 – 2%)
Núcleo bilobado, grânulos citoplasmáticos azuis escuros, grosseiros
Função imune, alergia, produção de histaminase, resposta a parasitas
Resposta inflamatória, alergia, secreção de histamina, serotonina, heparina, entre outros
(Coloração May-Grünwald-Giemsa, ampliação inicial 10x50); * valor absoluto (±2 SD) (valor percentual); diâmetro; ♂ homem; ♀ mulher; Ac – anticorpos; NET – neutrophil extracellular traps; NK – natural kller; SD – desvio-padrão.
Tabela 10.2.1 – Características dos sopros associados às formas mais frequentes de valvulopatia.
Doença valvular
Sopro Localização no ciclo cardíaco Contorno acústico Foco predominante Irradiação
Estenose aórtica Mesossistólico
Insuficiência aórtica Diastólico
Estenose mitral Diastólico



Insuficiência mitral Holossistólico
Insuficiência tricúspide

Holossistólico

Aórtico
Doença Cardíaca Valvular
Resposta a manobras que aumentam a pré ‑carga
Resposta a manobras que aumentam a pós‑carga
Carotídea +++ Axilar +
BEE/BED N.A.
Axilar +++ Focos base +
inferior Rebordo costal direito
AM – abertura da válvula mitral; ATric – abertura da válvula tricúspide; BED – bordo esternal direito; BEE – bordo esternal esquerdo; EA – estalido de abertura mitral.
Hipertrofia concêntrica
Sobrecarga de pressão
Hipertrofia excêntrica
Sobrecarga de volume
Lei de Laplace
Figura 10.2.1 – De acordo com a lei de Laplace, a tensão de parede miocárdica (T) é diretamente proporcional à pressão intra cavitária (P) e ao raio da câmara ventricular (r), e inversamente proporcional à espessura da parede (e). Em condições caracte rizadas por stress hemodinâmico crónico, quer com sobrecarga de pressão quer com sobrecarga de volume, o VE adapta‑se com fenómenos de hipertrofia concêntrica e excêntrica, respetivamente. Estas alterações visam a normalização da tensão de parede, e, portanto, da pós‑carga ventricular esquerda. (Adaptado de Nadruz, 2015)
Estímulo lesivo
(exemplo: isquemia, cardiomiopatia, doença in ltrativa, doença valvular)
Morte de cardiomiócitos
Ativação direta
Ativação indireta por células pró- bróticas (exemplo: células endoteliais e in amatórias)
Ativação SRAA
Mediada por fatores de crescimento de citocinas pró-in amatórias
TGF-β
Diferenciação
Proliferação de broblastos
miRNA MMP Gal-3
Endotelina
Mio broblasto
Deposição de colagénio
Fibrose miocárdica
Figura 10.3.7 – A resposta fibrótica na IC envolve uma interação complexa entre células pró‑fibróticas circulantes, fatores de crescimento, hormonas e citocinas pró ‑inflamatórias. A apoptose de cardiomiócitos pode resultar de um insulto cardíaco primário (por exemplo, isquemia) ou no contexto de doença sistémica (por exemplo, HTA) e tem como consequência a proliferação local de fibroblastos. A sua ativação pode ser direta, por intermédio de proteínas de sinalização celular, microRNA e metaloproteinases da matriz (MMP); ou indireta, por meio de mediadores pró ‑fibróticos circulantes, como células endoteliais, epiteliais e inflamatórias. Os fibroblastos cardíacos diferenciam‑se em miofibroblastos sob o estímulo do fator de crescimento do tecido conjuntivo (CTGF), fator de crescimento tecidular‑β (TGF β), fator de necrose tumoral α (TNF α), sistema renina‑angiotensina‑aldosterona (SRAA), galectina‑3 (Gal‑3), endotelina e interleucina‑11 (IL‑11). A via final comum da resposta fibrótica ao nível cardíaco envolve a deposição de colágeno (dos miofibroblastos) na MEC. (Adaptado de Webber et al., 2020)
4.4 Patogenia da insuficiência cardíaca de fração de ejeção preservada
A insuficiência cardíaca de fração de ejeção preservada é uma entidade heterogénea, englobando cerca de 50% dos casos de IC. Esta entidade apresenta‑se sobretudo em populações mais idosas, sendo mais frequente no sexo feminino, e em doentes com múltiplas comorbilidades. Simplificando a sua complexa fisiopatologia, pode dizer se que se trata de uma doença sistémica multifatorial. Na sua patogénese encontram‑se fatores metabólicos
(obesidade, diabetes mellitus), HTA, fibrilha ção auricular, alterações cardíacas morfofun cionais relacionadas com inflamação, stress oxidativo, alterações degenerativas, disfunção endotelial e microvascular, desacoplamento ventrículo‑arterial, alterações periféricas ao nível do consumo de O2, incompetência cro notrópica, entre tantos outros (Figura 10.3.8). Todos estes fatores, isoladamente ou em com binação, irão promover elevação das pressões de enchimento e disfunção diastólica, com as consequentes manifestações clínicas de IC.





Figura 12.4.2 – Patologia de diferentes mecanismos na doença renal crónica. (A) Glomérulo normal; (B) Glomérulo com lesão crescêntica numa doente com nefrite lúpica; (C) Glomeruloesclerose nodular num doente com nefropatia diabética; (D) Arteriosclerose severa num doente com hipertensão arterial; (E) Arteriosclerose severa, fibrose intersticial, atrofia tubular e um glomérulo com glomeruloesclerose global. (A, B, D, E com coloração ácido periódico‑Schiff, ampliação de 200x; (C) com coloração tricrómio de Masson, ampliação de 200x). (Imagens gentilmente cedidas pelo arquivo anatomopatológico do Serviço de Nefrologia do Centro Hospitalar e Universitário de Coimbra)
Do ponto de vista morfológico, o comparti mento do túbulo intersticial do rim ocupa mais de 90% do volume renal normal. Na DRC, foi demonstrado que existe uma estreita correla ção entre o declínio da TFG, a proteinúria e a progressão de fibrose intersticial/atrofia tubu lar. Mesmo nas doenças que começam por atingir o glomérulo, com o avanço do tempo observa‑se o envolvimento progressivo do compartimento tubular e intersticial. As células do epitélio tubular, quando em contacto com as proteínas filtradas, como a albumina e com plemento, ou após reabsorção, aumentam a expressão de moléculas de adesão e são esti muladas a produzir moléculas inflamatórias com potencial pró‑fibrótico. Estas moléculas são sobretudo espécies reativas de oxigénio e quimocinas, que, por sua vez, atraem célu las inflamatórias para o interstício (células T, monócitos e macrófagos). Estas células,
através de sinalização parácrina, interagem com as células periadventícias dos capilares peritubulares, os fibroblastos do interstício e as próprias células do epitélio tubular, induzindo ‑as à transformação em miofibroblastos, célu las caracterizadas por neoexpressar o fenótipo da α‑actina no citoesqueleto. Estas células, de morfologia contráctil, têm a capacidade de sintetizar componentes da MEC (isto é, colagé nio). Com o avanço da doença e a expansão do fenómeno fibrótico das células epiteliais, estas perdem a capacidade regenerativa e sofrem apoptose. Como referido, ao nível do interstício a rede de microcirculação peritubular desem penha uma função extremamente importante neste órgão de grande atividade metabólica e elevado consumo de oxigénio. Numa fase ainda inicial da doença, esta microcirculação torna‑se permeável às proteínas do plasma, cuja passagem para o interstício desenca deia uma resposta inflamatória que envolve e destrói os capilares (síndrome de fuga capilar
Fisiopatologia – bases da medicina clínica
A ejaculação e a detumescência resultam da es timulação do sistema nervoso simpático (SNS).
A fisiopatologia da DE é normalmente multifa torial. No entanto, pode classificar‑se em vas culogénica (em resultado de hábitos tabágicos, obesidade, doenças cardiovasculares como hipertensão arterial – HTA e coronariopatia, DM, cirurgia pélvica), neurogénica (consequência de AVC, doenças degenerativas – EM, doença de Parkinson, polineuropatia, DM), anatómica (em doentes com hipospádias; fimose, cancro do pénis, doença de Peyronie), hormonal (em doentes com diabetes, síndrome metabólica, hipertiroidismo, hipogonadismo), psicogénica ou induzida por drogas (anti‑hipertensores, antiandrogénios, antidepressivos e antipsicó ticos, cocaína, heroína, marijuana, esteroides anabolizantes).
A DE está associada a múltiplos fatores de risco, de onde se destacam: a idade, a DM, a dislipi demia, a HTA, a doença cardiovascular, a obesi dade, a síndrome metabólica, a falta de exercício físico e o tabaco. A fibrilhação auricular, hiperti roidismo, défice de vitamina D, hiperuricemia, depressão, insuficiência renal crónica e doença pulmonar obstrutiva crónica são também fato res de risco para DE.
O diagnóstico baseia‑se numa história clínica detalhada (antecedentes patológicos, histórica sexual e psicossocial), no exame físico cuida doso (focado nos sistemas geniturinário, endó crino, vascular e neurológico) e nos resultados dos exames laboratoriais solicitados. Na ava liação destes doentes, é fundamental ter em consideração todos os fatores de risco (vascu lares, neurogénicos, hormonais). A avaliação laboratorial deve ser orientada para o doente e respetivos fatores de risco (por exemplo: glice mia em jejum; hemoglobina glicada – HbA1C, perfil lipídico), bem como para a avaliação hor monal (testosterona, antigénio específico da próstata – PSA, prolactina, hormona luteínica). Outros estudos podem também ser usados no diagnóstico: avaliação da tumescência e rigidez noturna (RigiScan®) e estudos vasculares (injeção intracavernosa de droga vasoativa; eco‑Doppler peniano, cavernosografia e cavernosometria).
O cancro do rim representa cerca de 3% de todos os cancros, com cerca de 431 288 novos diagnósticos em todo o mundo e 1191 em Por tugal, em 2020. No mesmo ano, estima‑se que tenham morrido em todo o mundo 179 369 indivíduos e 524 em Portugal.
O cancro do rim compreende uma variedade de distintos subtipos com alterações histológi cas e moleculares. Dentro destes, destaca‑se o carcinoma de células renais (CCR) – um adeno carcinoma que representa aproximadamente 90% das neoplasias renais (Figura 15.3). O CCR divide‑se essencialmente em três grandes subtipos: células claras, papilar (tipo I e tipo II) e cromófobo. É mais prevalente em homens com um rácio 1,5 e surge com maior prevalên cia em indivíduos mais velhos.

Figura 15.3 – Macroscopia de carcinoma de células renais em rim com cálculos urinários. (imagem gentilmente cedida pelo Doutor João lobo, serviço de anatomia patológica do ipo porto)
Fisiopatologia
Estes períodos de despolarização prolongados mantêm o potencial de membrana acima do limiar de geração de potenciais de ação media dos pelos canais de sódio, justificando esta hiperexcitabilidade. Ao PDS, segue‑se uma hiperpolarização prolongada que determina o término dos potenciais de ação. Mas se a exci tabilidade se tornar excessiva, ou os mecanis mos inibitórios falharem, a hiperpolarização pode não ser eficaz, mantendo o potencial de membrana acima do limiar. As descargas podem prolongar‑se, ativando neurónios vizi nhos e recrutando um grupo suficiente de neu rónios para gerar uma crise.
Vários mecanismos podem contribuir para esta excitabilidade e para a geração de crises. Por um lado, existem mecanismos em que há diminuição da inibição, por defeito da inibição mediada pelos recetores GABAA e GABAB ou por defeito na ativa ção dos neurónios GABA. Por exemplo, mutações que induzem redução ou ausência da expressão de subunidades dos recetores GABAA, como na síndrome de Angelman. Por outro lado, existem mecanismos de aumento da ativação, por res posta prolongada aos recetores NMDA, manten do a entrada de Ca2+ e permitindo a manutenção dos PDS, ou por aumento da sincronização neu ronal secundária a fenómenos não sinápticos
(efáticos), que permitem recrutar áreas vizinhas. Outro mecanismo de aumento da ativação, e que foi descrito para a epilepsia temporal com esclerose do hipocampo – uma das formas mais frequentes de epilepsia focal –, é a ativação colateral recorrente. Este fenómeno decorre do crescimento axonal anormal de neurónios es pecíficos, desencadeado pela degeneração dos neurónios que condicionaram a esclerose do hi pocampo. Este crescimento anormal gera cone xões excitatórias aberrantes para a própria célula e células vizinhas, condicionando autoestimula ção e ativação colateral recorrente, aumentando a hiperexcitabilidade e a sincronização.
A epilepsia de ausências é o exemplo de epilepsia generalizada mais bem estudada e que permitiu demonstrar a ligação e modulação tala mocortical na geração de crises. Este circuito inclui os neurónios piramidais neocorticais, os neurónios talâmicos de retransmissão e os neu rónios do núcleo reticular do tálamo (NRT).
Em modelos animais, foi possível demonstrar que neurónios do NRT inibem os neurónios de retransmissão, regulando a ativação de canais cálcio do tipo T. Estes canais de cálcio têm três
Figura 16.1 – Períodos de despolarização prolongados estão na origem das crises focais, que podem posteriormente generalizarse. (A) Crises de início focal, que começam em redes locais, lateralizadas a um hemisfério. Contudo, este tipo de crises podem posteriormente generalizarse, através da propagação da atividade pelo corpo caloso ou envolvendo estruturas subcorticais como o tálamo (a azul); (B) Num foco epilético, no período interictal (isto é, entre crises), ocorrem surtos de alta frequência de potenciais de ação associados a períodos muito longos de despolarização da membrana celular, denominados de PDS, aos quais correspondem no EEG a ponta onda lenta.
Trompomiosina
Sítio de ligação Troponina
Mio lamento de actina
Filamentos de actina
Molécula de miosina Cabeça Haste
Mio lamento de miosina


Tendão
Osso


Músculo esquelético
Vaso sanguíneo
Fascículo muscular Fibra muscular (célula)
Epimísio
Perimísio
Endomísio
Sarcómero
Disco z
Túbulo transverso Mitocôndria
Núcleo Retículo sarcoplasmático Sarcolema (membrana celular) Capilar
Figura 17.2 – A figura detalha a organização hierárquica do tecido muscular, desde a estrutura macroscópica até os componentes microscópicos, destacando a importância de cada nível para a função muscular. Um músculo esquelético, como o bicípite braquial representado na figura, é composto por vários feixes musculares, designados de fascículos, que se encontram envoltos por uma camada de tecido conjuntivo designada de epimísio. Cada fascículo, envolto pelo perimísio, é constituído por fibras musculares, que por sua vez se encontram envolvidas no endomísio. Todas as fibras musculares consistem em miofibrilhas, constituídas por miofilamentos individuais de actina e miosina, organizadas em unidades contrácteis, os sarcómeros. (Fonte: ver final do capítulo)
complexo major de histocompatibilidade (MHC) classe I, responsáveis pela apresentação de antigénios endógenos ao sistema imune, sendo esta uma característica diferenciadora das célu las musculares. Até à data, é ainda desconhe cida a razão de tal acontecimento.
A unidade funcional das fibras musculares é a miofibrilha, composta maioritariamente (85%) por proteínas de actina e miosina, mas tam bém por proteínas estruturais ou reguladoras, como a tropomiosina, troponina, desmina e titina, estando revestida por uma membrana, o sarcolema. À unidade contráctil das miofi brilhas atribui‑se a designação de sarcómero, responsável pelo impulsionar da força e movi mento rápido e extremamente coordenado,
característico das formas de vida mais com plexas. A sua estrutura é composta maiorita riamente por filamentos de actina e miosina, paralelos entre si e ao eixo da fibra muscular, e, nas extremidades, identificam‑se os discos Z que separam sarcómeros adjacentes.
O ME encontra‑se sob controlo voluntário, dependendo de um estímulo nervoso recebido pelas placas motoras terminais das fibras mus culares para o desencadear da sua atividade contráctil e, deste modo, do movimento. O pro cesso de contração muscular é dependente de iões de cálcio e da atividade da miosina ade nosina trifosfatase, associada à molécula de miosina, que pode assumir diferentes isofor mas com diferentes propriedades contrácteis.
Hiperplasia
Acantose
Espongiose In amação Prurido
Figura 19.3 – Inflamação na dermatite atópica. Envolvimento das células Th-2, produtoras de IL-4, IL-13, IL-5 e IL-31, responsáveis pela inflamação dermoepidérmica, pela disrupção da barreira epidérmica e pela estimulação das terminações nervosas, causando prurido. Os queratinócitos produzem “alarminas” (IL-33) e TSLP, que ativam as ILC e promovem o desvio da resposta Th-2. Contributo ainda de outras células T, nomeadamente das células Th-22 (responsáveis pela hiperplasia epidérmica) e das células Th-1 e Th-17, sobretudo em fases mais crónicas da dermatite atópica. (Adaptado de Krohn et al., 2021) IL – interleucina; ILC – células linfoides inatas; TSLP – linfopoietina estromal tímica. Células
O prurido, frequente em patologia cutânea, é um dos sintomas major da dermatite atópica, mas pode ocorrer também noutras situações de xero se cutânea, como na pele senil, em que o estrato córneo se torna mais fino, aplanado e com menor capacidade de reparação; em doenças alérgicas, como a urticária e a dermatite de contacto alérgica (DCA); em doenças metabólicas, como a diabetes mellitus (DM), a colestase hepática ou a insuficiência renal; em infeções e infestações, como a sarcoptose (vulgarmente conhecida por sarna); e mesmo em doenças autoimunes, como a dermatomiosite. A IL‑31, uma citocina produzida sobretudo pelas células Th 2, é o principal media dor do prurido nestas dermatoses. Esta citocina, um verdadeiro comunicador neuroimunológico, tem um efeito pró‑inflamatório nas células epite liais, mas atua sobretudo nas terminações nervo sas sensitivas onde fosforila e dimeriza as duas subunidades do seu recetor (IL‑31RA e oncostatin M receptor β – OSMRβ) e transmite a sensação de prurido ao sistema nervoso central (SNC), que comanda a reação de coçar. Simultaneamente, a IL‑31 promove o crescimento das terminações ner vosas sensitivas da pele que atingem camadas mais superficiais da epiderme, aumentando a sua acessibilidade aos estímulos pruritogénicos.
A patogénese da dermatite atópica é complexa, estando associada a um componente hereditá rio – foram identificadas alterações genéticas da barreira epidérmica, como as mutações da filagrina (uma das principais proteínas respon sável pela formação de NMF nos queratinóci tos e corneócitos) ou do sistema imunitário, como um desvio da resposta imunitária para Th 2 e produção de IgE. Não é, contudo, des prezível o contributo dos fatores ambientais (baixa humidade, irritantes químicos, poluição, alergénios ambientais, como ácaros, pólenes ou fâneros, plantas, alimentos e disbiose). Nestes indivíduos com alterações primárias ou secundárias da resposta imune, estabelece ‑se um círculo vicioso de disfunção da barreira epidérmica e inflamação crónica com envolvi mento de linfócitos Th 2, Th 1, Th 17 e Th 22, prurido intolerável e coceira, perda da integri dade cutânea, maior penetração de irritantes e alergénios, maior colonização por Staphylococcus aureus e maior inflamação (eczema), que culmina numa dermatose crónica liquenificada altamente invalidante quando o círculo não é interrompido atempadamente.
Experiência
Traços de personalidade
Predisposição genética
Epigenética
Stress Psicológico
Vias límbicas
Processamento cortical
Stress Fisiológico
Vias não límbicas
Ausência de processamento cor tical
Coluna intermediolateral
Resposta aguda de stress A
SN simpático e catecolaminas Arousal
Glicocorticoides
Mecanismos de coping

Ansiedade/medo
Estado de aler ta Hiper vigilância Memorização

Hipó se
B Stress crónico
Resposta Compor tamental
Córtex pré-frontal

Hipocampo
Amígdala
Resposta siológic a
Hipotálamo
Terceiro ventrículo
Adeno-hipó se
Catecolaminas
Plasticidade sináptica
Modi cação de células microgliais
Dopamina e 5-HT
Glicocorticoides
Núcleo paraventricular
Eminência mediana
Neuro-hipó se
Vasopressina
Cor ticotro na
Suprarrenal
Medula Córtex
Glicocorticoides
Adaptação
Exaustão
Sobrecarga alostática
E cácia da resposta
Carga alostática
Meses/Anos
Consequências da sobrecarga alostática
Neuropsicológicas
• depressão
• ansiedade
• fobias
• dé ces mnésicos
• dé ces cognitivos
• compor tamentos aditivos
• disfunção sexual
Sistémicas
• taquicardia
• vasoconstrição
• retenção de sal e água
• hipercolesterolemia
• obsidade central
• insulinorresistência
• aterosclerose
• hipercoagulabilidade
• imunossupressão
Figura 21.1 – Visão integrada dos mecanismos fisiopatológicos associados ao stress. Esquema integrativo que ilustra os mecanismos de resposta ao stress, a sequência de ativação na resposta aguda (A), a transição para a patologia no stress crónico (B) e as principais consequências da sobrecarga alostática (C).
5-HT – 5-hidroxitriptamina ou serotonina; SN – sistema nervoso.
As respostas comportamentais centrais consti tuem a redução dos limiares sensoriais e cog nitivos, conduzindo a um estado geral de alerta do SNC e à supressão dos comportamentos associados à reprodução e alimentação. No cerne desta resposta, está o locus coeruleus (LC), principal local de produção de noradre nalina e ativador do SNC, e a ativação de vias monoaminérgicas da formação reticular, com modificação dos padrões eletroencefalográ ficos evidenciando maior preponderância de ondas de alta frequência e baixa amplitude, típicas do estado de vigília, e aumento ime diato do metabolismo e atividade cerebrais. Os mecanismos moleculares e genéticos envolvi dos ainda estão em investigação. Sob o ponto de vista psicológico e emocional, invariavel mente, o stress faz‑se acompanhar de medo e ansiedade, correspondendo o medo ao alarme psicológico perante perceção de ameaça e a ansiedade à antecipação desta.
Os trabalhos originais de Cannon e Selye para estímulos stressantes major no reino animal, assim como os mecanismos de arousal, suge rem uma resposta estereotipada. No entanto, esta visão tem‑se revelado extremamente redutora no contexto do ser humano. As inves tigações mais recentes identificaram múltiplas vias e mecanismos diversificados de resposta no SN, e diversos estímulos stressantes de várias magnitudes revelaram facetas específi cas para cada estímulo, com assinaturas dis tintas no que toca ao padrão de libertação de hormonas e neuropeptídeos.
O hipotálamo, como centro orquestrador neuro endócrino das vias de stress, coordena a maior parte da resposta endócrina e do sistema ner voso autónomo (SNA) através de um conjunto de servomecanismos homeostáticos mediante
A siopatologia é o alicerce sobre o qual a medicina se constrói. É fundamental para a estruturação do raciocínio clínico, proporcionando bases teóricas e práticas para a compreensão das alterações funcionais que ocorrem nos sistemas do organismo humano, quando confrontado com patologias e disfunções, incluindo também a sistematização das causas das doenças. Permite, assim, desenvolver aptidões de análise, crítica e síntese, necessárias para uma prática clínica baseada em evidência. Por este motivo, é crucial que a siopatologia tenha um papel central na formação médica, garantindo que os estudantes estejam devidamente preparados para enfrentar os desa os clínicos.
Este livro, com a colaboração de Professores de prestigiadas escolas médicas portuguesas, especialistas de renome das respetivas áreas, é uma ferramenta consolidada e cuidadosamente desenvolvida, com o objetivo de promover a excelência académica e contribuir para a formação de pro ssionais de saúde.
Foi elaborado para proporcionar aos alunos de medicina uma abordagem clara e abrangente da siopatologia, com uma organização lógica e sequencial, permitindo uma progressão gradual desde os conceitos fundamentais até aos de maior complexidade. Os conteúdos estão, sempre que possível, enriquecidos com + de 90 quadros e tabelas, + de 130 guras e cerca de 20 ilustrações, inúmeros exemplos clínicos relevantes e estudos de caso, com o objetivo de auxiliar na aplicação prática do conhecimento.

